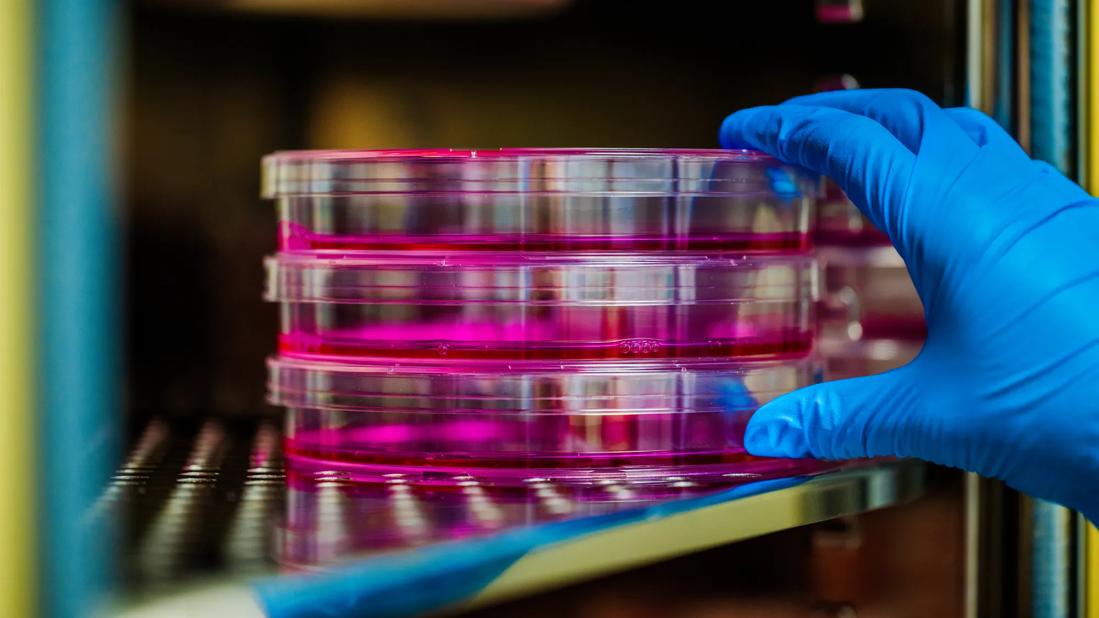

Cleveland Clinic forms Global Center for Pathogen Research & Human Health
Image content: This image is available to view online.
View image online (https://assets.clevelandclinic.org/transform/64c5c496-5a3c-44d0-8f49-d3447d81c901/LRI_5740558_03-13-25_066_SCG)
650×450-Global-Center-for-Pathogen-Research-&-Human-Health
As part of the new Cleveland Innovation District announced recently by State of Ohio Governor Mike DeWine, Lieutenant Governor Jon Husted, JobsOhio and Ohio Development Services Agency, Cleveland Clinic will significantly expand its global commitment to infectious disease research and translational programs to form the Global Center for Pathogen Research & Human Health.
Advertisement
Cleveland Clinic is a non-profit academic medical center. Advertising on our site helps support our mission. We do not endorse non-Cleveland Clinic products or services. Policy
The new Center will position Ohio as an international leader for research into emerging pathogens and virus-related diseases and will serve as a significant economic catalyst in Northeast Ohio. Funding comes through a $500 million investment from the State of Ohio, JobsOhio and Cleveland Clinic.
“The Cleveland Innovation District creates partnerships across different sectors of the economy and positions Ohio as a competitive place to invest in,” said Governor Mike DeWine. “Each of the Cleveland Innovation District partners bring unique skills and areas of expertise. Having these institutions partner together will help Ohio emerge as a leader in healthcare and IT nationally and globally.”
The State of Ohio and JobsOhio will invest $200 million to help launch the Center and Cleveland Clinic plans an additional $300 million as a co-investment to fuel discoveries in our new and existing research facilities. Further, the Center will create new start-up technology companies in the Cleveland Innovation District, attract world-leading corporations to Ohio, and generate an estimated 1,000 new jobs at Cleveland Clinic by 2029 and an additional 7,500 jobs in Ohio by 2034.
“We are exceedingly grateful to Governor DeWine, Lieutenant Governor Husted, JobsOhio and Ohio Development Service Agency for their extraordinary vision for economic development and research in Ohio,” said Cleveland Clinic CEO and President Tom Mihaljevic, MD. “This is the largest research effort in Cleveland Clinic’s 100-year history. The Global Center for Pathogen Research & Human Health will put Cleveland, Ohio at the forefront of pathogen research and preparing for the next pandemic or healthcare crisis. The Center will have a significant impact on global health, while creating jobs and educational opportunities in Ohio.”
Advertisement
Headquartered in Cleveland and spanning Cleveland Clinic’s international footprint in Florida, London and Abu Dhabi, the Global Center for Pathogen Research & Human Health will bring together a research team focused on broadening understanding of viral pathogens, virus-induced cancers, genomics, immunology and immunotherapies. It will expand upon Cleveland Clinic’s existing programs and expertise, with newly recruited world leaders in immunology, cancer biology, immune-oncology and pathogen research as well as technology development and education. Researchers will expand critical work on studying, preparing and protecting against public health threats such as HIV/AIDS, Dengue fever, Zika and COVID-19.
“The Global Center for Pathogen Research & Human Health will be a command center to help solve deadly threats to our health, economy and communities,” said Serpil Erzurum, MD, Cleveland Clinic’s Chief Research and Academic Officer. “The unparalleled investment in the Center will drive workforce development while leveraging Cleveland Clinic’s research infrastructure to study pathogens and the immune system in novel ways to develop new diagnostic tests, vaccines and treatments.”
Cleveland Clinic, with its world-wide clinical and research operations, top scientists and physicians, medical educational programs and international funding, is uniquely positioned to be a global hub for state-of-the-art pathogen research, clinical care and serving as an incubator for rapid development, testing and deployment of diagnostics, medicines and vaccines. The Center is organized around six highly collaborative programs with multidisciplinary experts in virology and immunology; personalized medicine and genomics; population health; drug discovery; diagnostic development and integration of big data with patient care.
Advertisement
The Center is led by Jae Jung, PhD, an internationally renowned expert in virology and virus-induced cancers who has broken ground in the field of inflammation, immune-oncology and emerging pathogens. This team plans the recruitment of more than 300 scientists in the next 5-7 years.
The support of JobsOhio will position the Center to thrive not just as a research center but a commercial force that will drive new products, jobs and economic development in Ohio. Working closely with Cleveland Innovation District partner organizations Case Western Reserve University, Cleveland State, The MetroHealth System and University Hospitals, Cleveland Clinic will provide workforce development training for job opportunities as the Center expands.
“Through this unprecedented investment, we will establish educational and career opportunities for Ohioans with the goal of attracting and retaining the very best talent,” said Dr. Erzurum. “A major focus will be training the next generation of Ohio’s workforce for careers that are growing in science, education and health care. We are thrilled to be part of the Cleveland Innovation District which promises to transform Northeast Ohio into an economic engine for biomedicine.”
Advertisement
Advertisement
First full characterization of kidney microbiome unlocks potential to prevent kidney stones
Researchers identify potential path to retaining chemo sensitivity
Large-scale joint study links elevated TMAO blood levels and chronic kidney disease risk over time
Investigators are developing a deep learning model to predict health outcomes in ICUs.
Preclinical work promises large-scale data with minimal bias to inform development of clinical tests
Cleveland Clinic researchers pursue answers on basic science and clinical fronts
Study suggests sex-specific pathways show potential for sex-specific therapeutic approaches
Cleveland Clinic launches Quantum Innovation Catalyzer Program to help start-up companies access advanced research technology